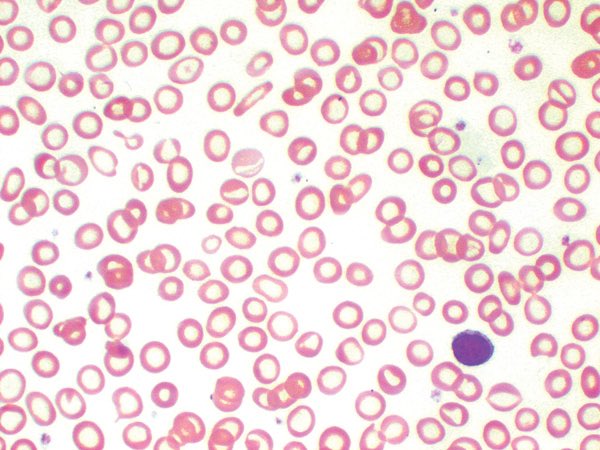
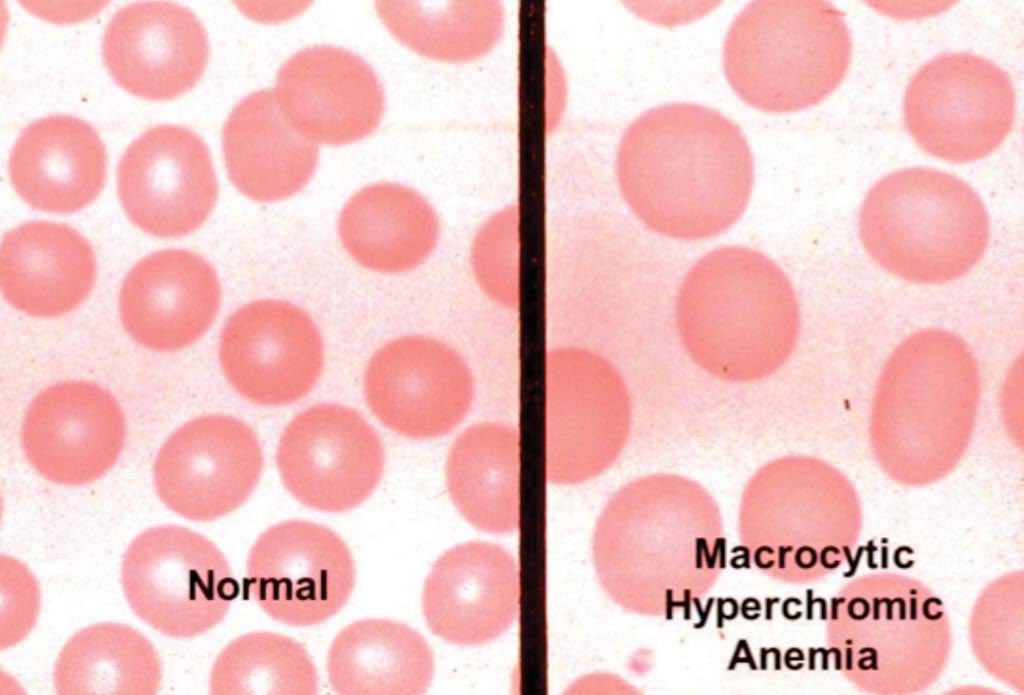
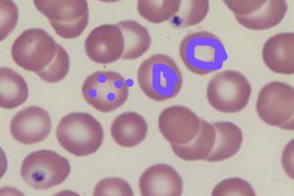
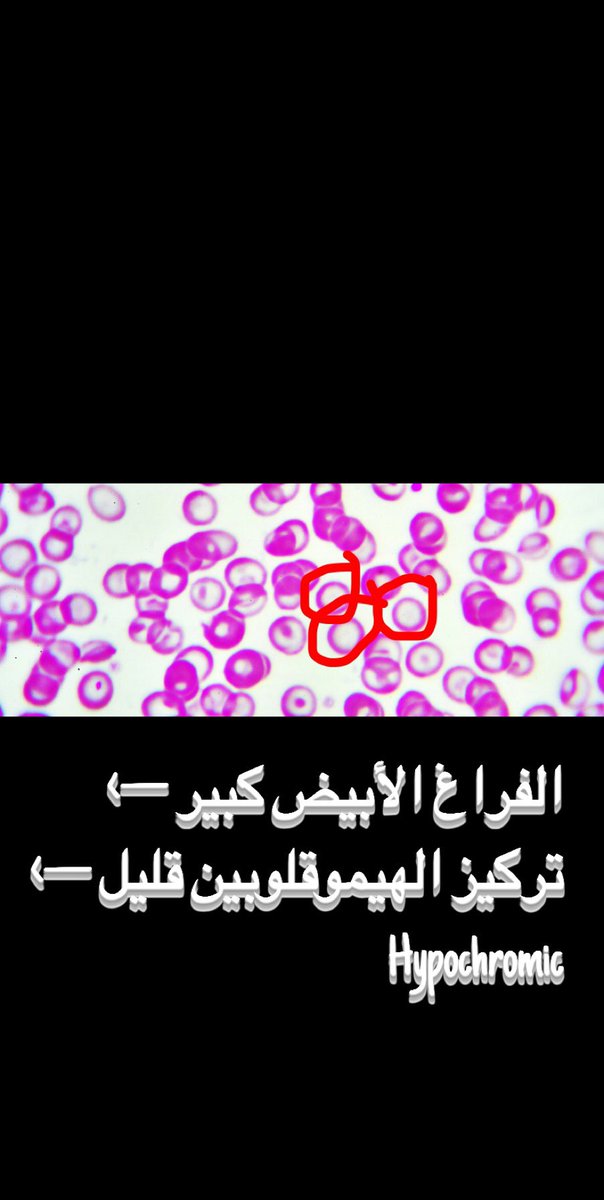
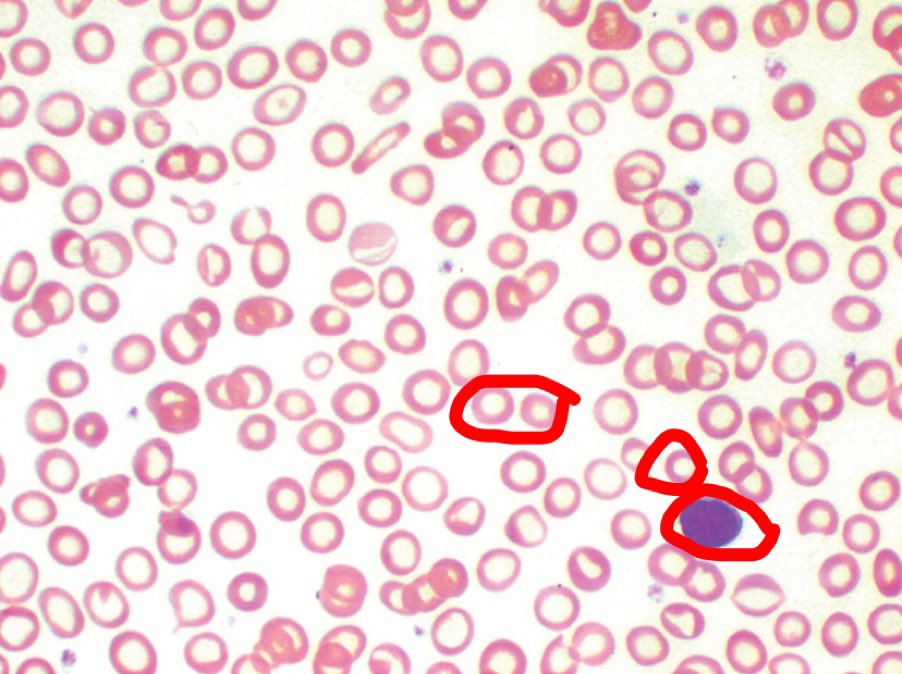

٩# التشخيص النهائي: 💁🏻♂️
Microcytic Hypochromic anemia
أشهر الأسباب:
•انيميا نقص الحديد
•انيميا الثلاسيميا
Microcytic Hypochromic anemia
أشهر الأسباب:
•انيميا نقص الحديد
•انيميا الثلاسيميا
جاري تحميل الاقتراحات...